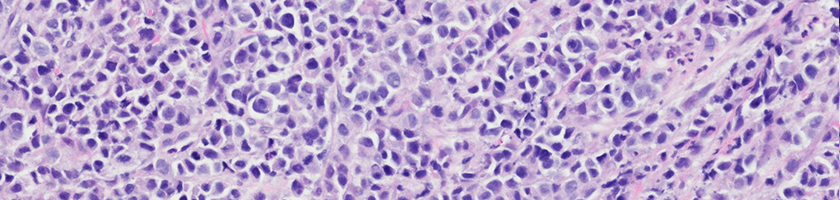
3_6 esophageal_cancer

Esophageal Cancer Screenings and Exams
You should think about screening if you're a smoker or have a family history of esophageal cancer.
Learn more about esophageal cancer screenings.
Explore this Section
Esophageal cancer is rare. Each year, doctors diagnose about 17,990 new esophageal cancer cases in the United States.
At UPMC Hillman Cancer Center, we have extensive experience in the care of people with esophageal cancer.
Our multidisciplinary team includes experts in:
We work together to individually tailor a treatment plan for your type and stage of esophageal cancer. And, we work with your referring doctor to ensure a complete team approach to your care.
Cancer is the result of abnormal and unchecked cell growth.
In esophageal cancer, tissues in the esophagus — the tube that connects the mouth to the stomach — begin to change and grow abnormally.
Esophageal cancer shares many traits in common with lung cancer.
Types of esophageal cancer are:
UPMC Hillman Cancer Center's extensive resources and expertise allow us to provide state-of-the-art, evidence-based care.
We are the only National Cancer Institute-designated Comprehensive Cancer Center in western Pennsylvania.
This means you have access to the latest esophageal cancer treatments through clinical trials. Many of these treatments may not be available elsewhere.
To learn more about Esophageal Cancer or to make an appointment, you can:

Esophageal Cancer Screenings and Exams
You should think about screening if you're a smoker or have a family history of esophageal cancer.
Learn more about esophageal cancer screenings.
Esophageal Cancer Treatment Program
UPMC Hillman Cancer Center's multidisciplinary approach to treating esophageal cancer means we can provide a complete continuum of care.
Learn more about our treatment program.
Treatments for Esophageal Cancer
There are many treatment options for esophageal cancer including medical oncology, radiation, and surgery.
Learn about esophageal cancer treatment options.